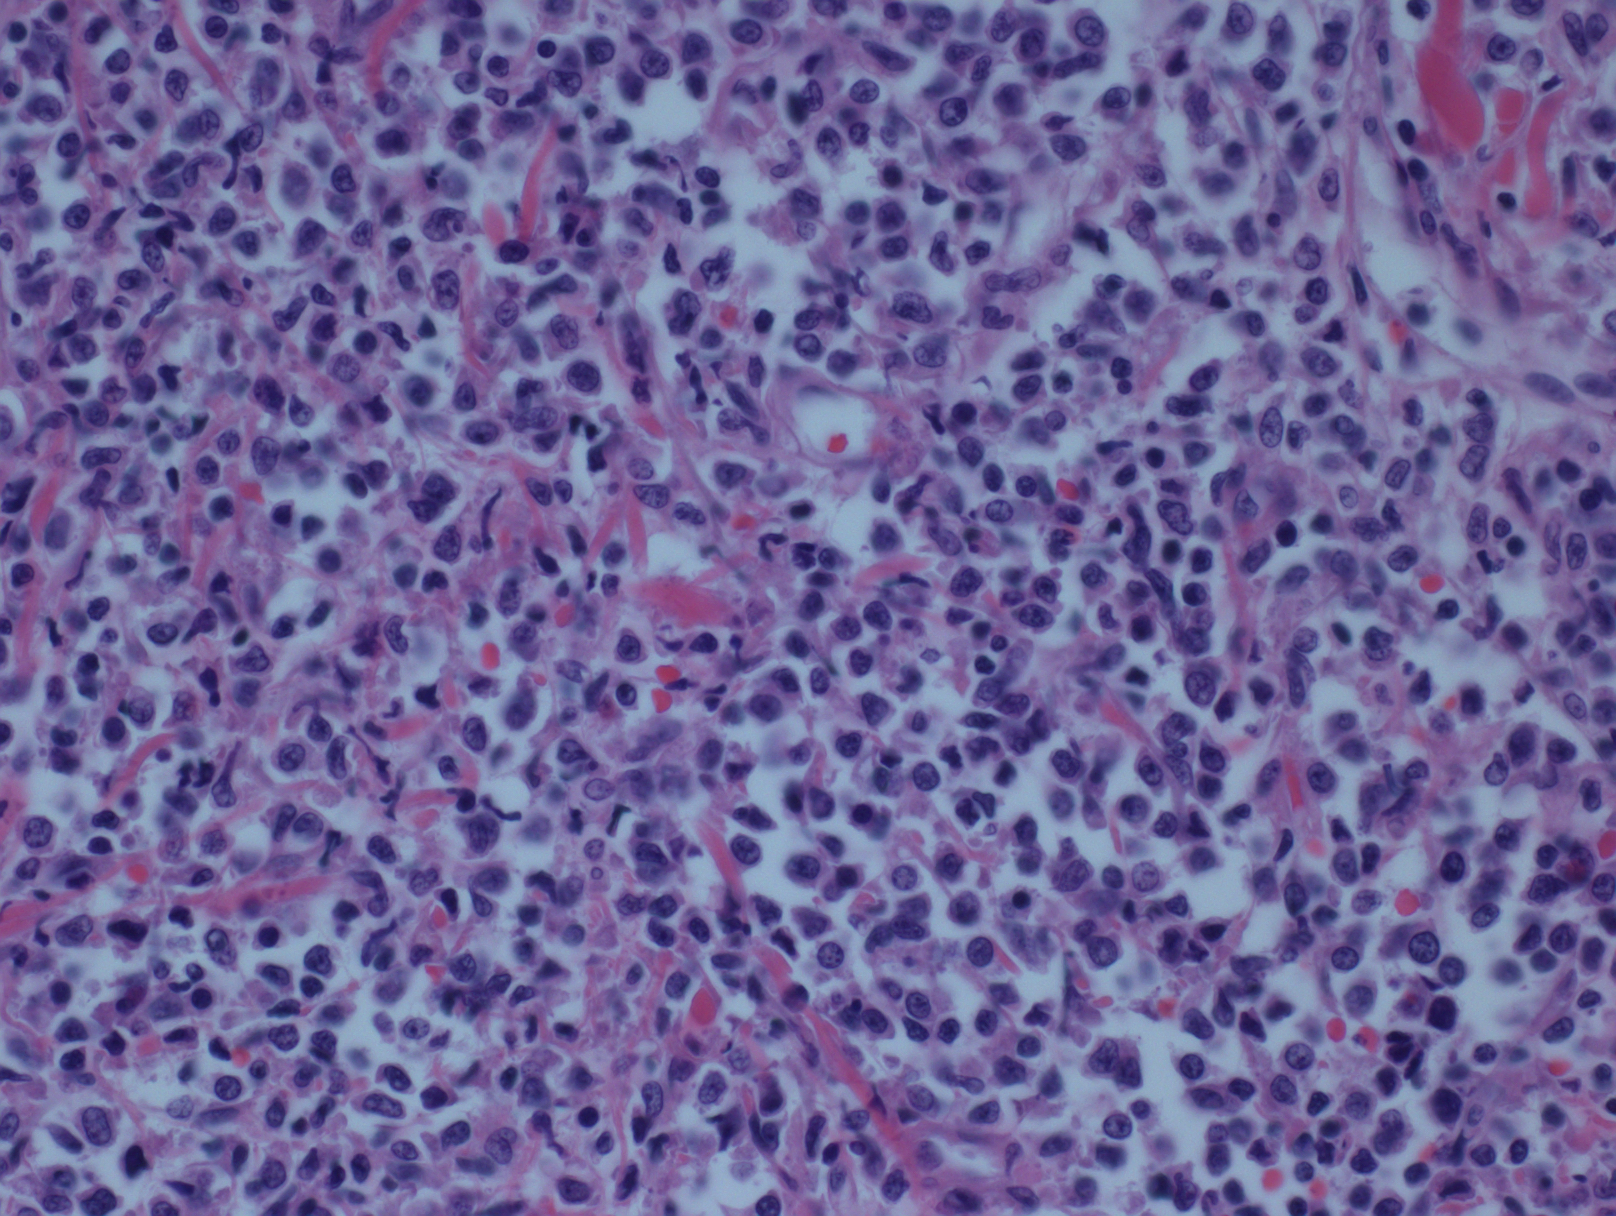

母细胞性浆细胞样树突细胞肿瘤
Blastic Plasmacytoid Dendritic Cell Neoplasm (BPDCN)
概述:
母细胞性浆细胞样树突细胞肿瘤是一种罕见的血液系统恶性肿瘤,来源于未成熟浆细胞样树突细胞,临床表现为侵袭性,最常见侵犯皮肤并累及骨髓和外周血及全身播撒。
诊断要点:
罕见,通常为老年人(61-67 岁),男性较多;儿童也可发病。累及多部位,最常见部位是皮肤(几乎 100%),其次分别是骨髓、外周血、淋巴结。皮肤可表现为结节(最多)、丘疹或斑块。少数病例一开始就表现为白血病,无皮肤累及。
形态学:肿瘤细胞呈现弥漫生长,具母细胞特征(可类似淋巴母细胞或髓系母细胞):中等大小、形态单一、核轻度不规则、染色质细腻、一到多个核仁、胞质细少,无颗粒。在皮肤,通常浸润真皮,最终延及皮下,但不累及表皮;在骨髓,呈现稀少或成片间质浸润,涂片有时可见肿瘤细胞有膜下微小空泡及包膜伪足;在淋巴结,常侵犯髓区或滤泡间(白血病侵犯模式)。一般不出现凝固性坏死和血管中心性浸润。
免疫表型和细胞化学:肿瘤细胞表达 CD4. CD56. TCL1. CD123. CD2AP、SPIB、CD303. CD43,约 50%病例 CD68 阳性(胞质点状),30%病例 TdT 阳性,CD7 和 CD33 也常阳性,少数病例 CD2. CD36. CD38. CD79a 阳性,最近发现 TCF4 具有诊断意义,部分病例(特别是儿童)S100 有不同程度表达,也有少数病例表达 BCL6. BCL2. IRF4,约 17%的病例流式 CD34 阳性(组织切片阴性)。不表达 CD3. CD5. CD19. CD20. CD13. CD16. TIA1. 穿孔素、CD34(组化)、CD117(个别报道阳性)、MPO 和 lysozyme(有报道流式可阳性),EBER 阴性。在流式,肿瘤细胞表现为典型的弱 CD45 和强 CD123(母细胞设门),且同时表达 CD4. CD56. CD45RA,这一表达谱系被认为具有诊断特异性。肿瘤细胞 NSE、CAE、MPO 细胞化学染色阴性。
遗传学:无特异性的细胞遗传学改变,常有复杂核型。最常见的染色体异常包括 5q21 或 5q34、12p13、13q13-21、6q23-qter、15q 和-9。近来发现有很多体细胞基因突变,如 TET2. NRAS、ATM、MET、KRAS 等。

鉴别诊断:
髓系肉瘤 :特别是累及皮肤时,需注意鉴别。形态学上除单型性的原始细胞外,常混有分化成熟中的细胞。MPO、溶菌酶、CD34 常阳性。
急性髓系白血病伴单核分化 :除骨髓和外周血,也可累及髓外组织包括皮肤。肿瘤细胞较大、染色质疏松、核仁显著、胞质有颗粒,MPO、溶菌酶等髓系/单核系抗原标记阳性,CD34 也可能阳性。 需特别注意的是,这类白血病细胞也可表达 CD4. CD56. CD23。
淋巴母细胞淋巴瘤 :细胞形态有相似之处,但表达特异的 B 或 T 细胞抗原,如 CD19. CD79a、PAX5. 胞质 CD3 等;此外,TdT 均匀一致阳性,CD34 也可阳性。
外周 T 细胞淋巴瘤-非特指 :淋巴结肿大最常见,但也可累及皮肤。细胞大小形态较不规则,常混有炎性细胞,表达 T 细胞抗原如 CD3. CD5. CD2 等,T 细胞受体基因呈现克隆性重排。
结外 NK/T 细胞淋巴瘤,鼻型 : 可累皮肤,有时细胞大小及单型性与母细胞性浆细胞样树突细胞肿瘤有些相似,但常有血管中心性浸润和坏死,免疫组化 CD3+、CD56+、TIA1+、穿孔素+,EBER-is+。
成熟浆细胞样树突细胞增生:可累及皮肤(斑丘疹,罕见结节)、淋巴结和骨髓,局灶状增生,偶融合成片,但细胞构成为成熟浆细胞样树突细胞,CD56 阴性。其与髓系疾病,特别是慢性粒-单核细胞白血病有一定相关性。
预后:
临床表现为侵袭性,中为生存期为 10.0 - 19.8 个月。少数儿童生存期较长。化疗临床缓解的病例,骨髓移植可能是最好的延长生存期的方法。
